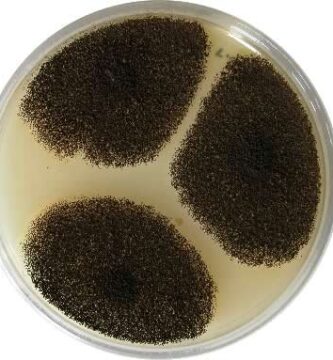

Hongos en la restauración de suelos contaminados por petróleo

Hongos en la eliminación de contaminantes emergentes en aguas residuales

Hongos en la fermentación de café

Hongos en la restauración de humedales degradados

Hongos en la conservación de monumentos históricos

Hongos en la biorremediación de metales pesados